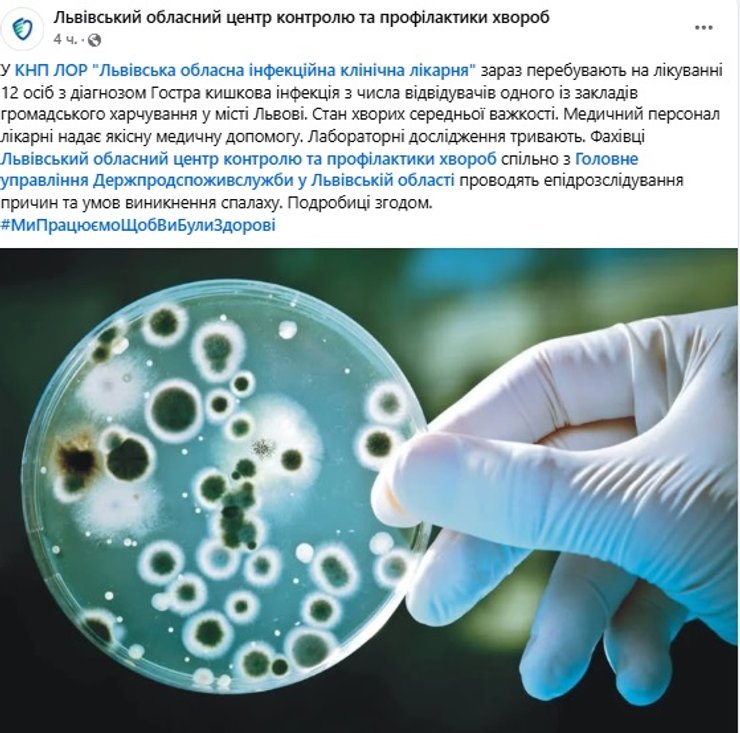

Отравление в ресторане Кацурина: полиция сообщает о 43 пострадавших

Местные Telegram-каналы сообщают, что среди отравившихся в ресторане "Китайский привет" есть несовершеннолетние. Врачи подозревают сальмонеллез, а инцидент в заведении официально подтверждает полиция.
Среди пострадавших – и сам ресторатор Михаил Кацурин, который находится в инфекционной больнице, сообщает паблик "Типичный Львов".
Сначала Telegram-каналы сообщали о 25 потерпевших, но по состоянию на 22:07 "Типичный Львов" озвучил цифру в 42 человека. Среди тех, кто отравился, – двое детей – 9 и 10 лет. Состояние большинства – средней тяжести.
В свою очередь Львовский областной центр контроля и профилактики болезней сообщил, что в областной инфекционной больнице находятся 12 человек с диагнозом "острая кишечная инфекция". Все они посещали одно из заведений общественного питания во Львове.
Специалисты Львовского областного центра контроля и профилактики болезней совместно с Главным управлением Госпродпотребслужбы во Львовской области проводят эпирасследование причин и условий возникновения вспышки.
По информации издания ZAXID.NET со ссылкой на и. о. заведующего 7-м отделением Львовской областной инфекционной больницы Михаила Когута, в отделении с симптомами острой кишечной инфекции в настоящее время находится восемь больных. Четверо обратились к врачам во вторник, 15 июля, а еще четверо – на следующий день.
"Пациенты жаловались на тошноту, рвоту, диарею, боль в животе и повышенную температуру тела. Предварительно им установили диагноз – острая кишечная инфекция. Результаты исследований будут со временем, но есть подозрение на сальмонеллез", – рассказал Михаил Когут.
Медицинский директор инфекционной больницы Андрей Орфин говорит, что больные могли отравиться десертом, но точная причина будет установлена после получения результатов исследований.
Ранее Михаил Кацурин обратился к подписчикам и клиентам через свой Instagram, где сообщил об инциденте. По его словам, сразу после случившегося ресторан сразу временно приостановил работу для выяснения обстоятельств. В заведение прибыла санитарная служба, которая проверила персонал, оборудование, кухню и остатки продуктов. Результаты анализов обещают сообщить пострадавшим и общественности.
Он пообещал полностью оплатить расходы на лечение всех пострадавших.
Когда готовился материал, стало известно, что по факту массового отравления в ресторане полиция открыла уголовное производство. В частности, возбуждено дело по ч.1 ст.325 (Нарушение санитарных правил и норм по предотвращению инфекционных заболеваний и массовых отравлений).
Санкция статьи предусматривает штраф, арест до шести месяцев и даже ограничение или лишение свободі на срок до трех лет.
Полицейские устанавливают происшествия, назначенные экспертизы, проводится досудебное расследование.
"По состоянию на 22.00, в медицинские учреждения с пищевым отравлением обратились 43 человека, из них трое детей", – добавили в полиции.
Напомним, Фокус писал, что на Закарпатье зафиксировано массовое отравление среди участников фестиваля.